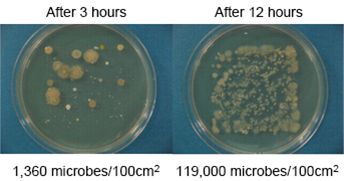
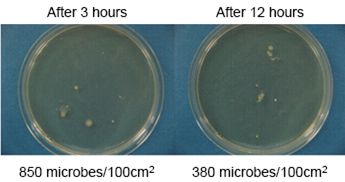

Dissolving type Antibacterial (NOVARON® AQ)
สารต้านแบคทีเรีย NOVARON® AQ (Silver-based)
NOVARON® AQ คือ สารต้านแบคทีเรียประเภทอนินทรีย์ในรูปแบบเม็ด ซึ่งเป็นการชะประจุเงินสำหรับการบำบัดน้ำ โดยการแช่ NOVARON® AQ ในถังเก็บน้ำต่าง ๆ หรือบริเวณที่ระบายน้ำทิ้ง ซึ่งสามารถยับยั้งการเน่าเสียของน้ำได้เป็นเวลานาน
คุณลักษณะ
ลักษณะเฉพาะ
- ออกฤทธิ์ต้านแบคทีเรียได้อย่างมีประสิทธิภาพต่อจุลินทรีย์หลายชนิด
- ค่อยๆ ปล่อยประจุเงิน (Ag+) และมีการออกฤทธิ์ที่ยาวนาน
- มีความปลอดภัยสูง และประยุกต์ใช้งานได้หลายแอพพลิเคชัน
- สะดวกต่อการใช้งาน เนื่องจากมีลักษณะเป็นเม็ด
รายละเอียดของผลิตภัณฑ์
คุณสมบัติทั่วไป
| ชนิด | NOVARON® AQ-24 | NOVARON® AQ-30B |
|---|---|---|
| ลักษณะภายนอก |  |
 |
| รูปร่าง | เกล็ดขนาด 1 ⁓ 6 mm | ครึ่งซีก ขนาดประมาณ 6 mm |
| ส่วนประกอบของเงิน | 2% | 2% |
| pH | กลาง ~ เบสอ่อน | กลาง ~ เบสอ่อน |
กลไกการทำงาน
ประจุเงินจาก NOVARON® AQ ที่ละลายในน้ำ เป็นตัวออกฤทธิ์กับเอนไซม์ของแบคทีเรียเพื่อยับยั้งการเจริญเติบโตและการทำงานของเมตาบอลิซึม
ความปลอดภัย
NOVARON® AQ ได้รับการยืนยันว่ามีความปลอดภัยสูง โดยการทดสอบความปลอดภัยที่หลากหลาย
ผลการทดสอบความปลอดภัยของ AQ-24
| รายการ | เงื่อนไขการทดสอบ | ผลการทดสอบ |
|---|---|---|
| ความเป็นพิษเฉียบพลัน ทางช่องปาก | OECD423 Rat(LD50) | > 5,000 mg/kg |
| การระคายเคืองทางผิวหนัง | OECD404 | P.I.I.=1.8 |
| อาการแพ้ทางผิวหนัง | OECD406(GPMTmethod) | เชิงลบ |
การประยุกต์ใช้งาน
ตัวอย่างการประยุกต์ใช้งาน
| เครื่องใช้ไฟฟ้า | เครื่องซักผ้า, เครื่องปรับอากาศ, เครื่องเพิ่มความชื้นในอากาศ, เครื่องลดความชื้นในอากาศ,เครื่องฟอกอากาศ |
|---|---|
| อื่น ๆ | อ่างอาบน้ำแบบระบบน้ำวน, หอทำความเย็น, เครื่องขัดพื้นสำหรับห้องพ่นสี |
ประสิทธิภาพของผลิตภัณฑ์
ตัวอย่างของการประยุกต์ใช้ในน้ำล้าง
ทำการซักและอบถุงตาข่ายที่มี NOVARON® AQ-24 อยู่ 30 g และผ้าโพลีเอสเตอร์ จากนั้นนำจุลินทรีย์บนพื้นผิวของผ้าโพลีเอสเตอร์ที่ผ่านการซัก 3 ชั่วโมง และ 12 ชั่วโมง ไปเพาะเลี้ยงบนอาหารเลี้ยงเชื้อแบบเจลทั่วไป (Regular agarose gel)
จุลินทรีย์บนผิวของผ้าโพลีเอสเตอร์ที่ถูกซักและอบโดยไม่มีถุงตาข่ายบรรจุ NOVARON®
จุลินทรีย์บนผิวของผ้าโพลีเอสเตอร์ที่ถูกซักและอบพร้อมถุงตาข่ายบรรจุ NOVARON®
เมื่อซักด้วย NOVARON® AQ พบว่า จำนวนเชื้อจุลินทรีย์ลดลงอย่างมีนัยสำคัญ
